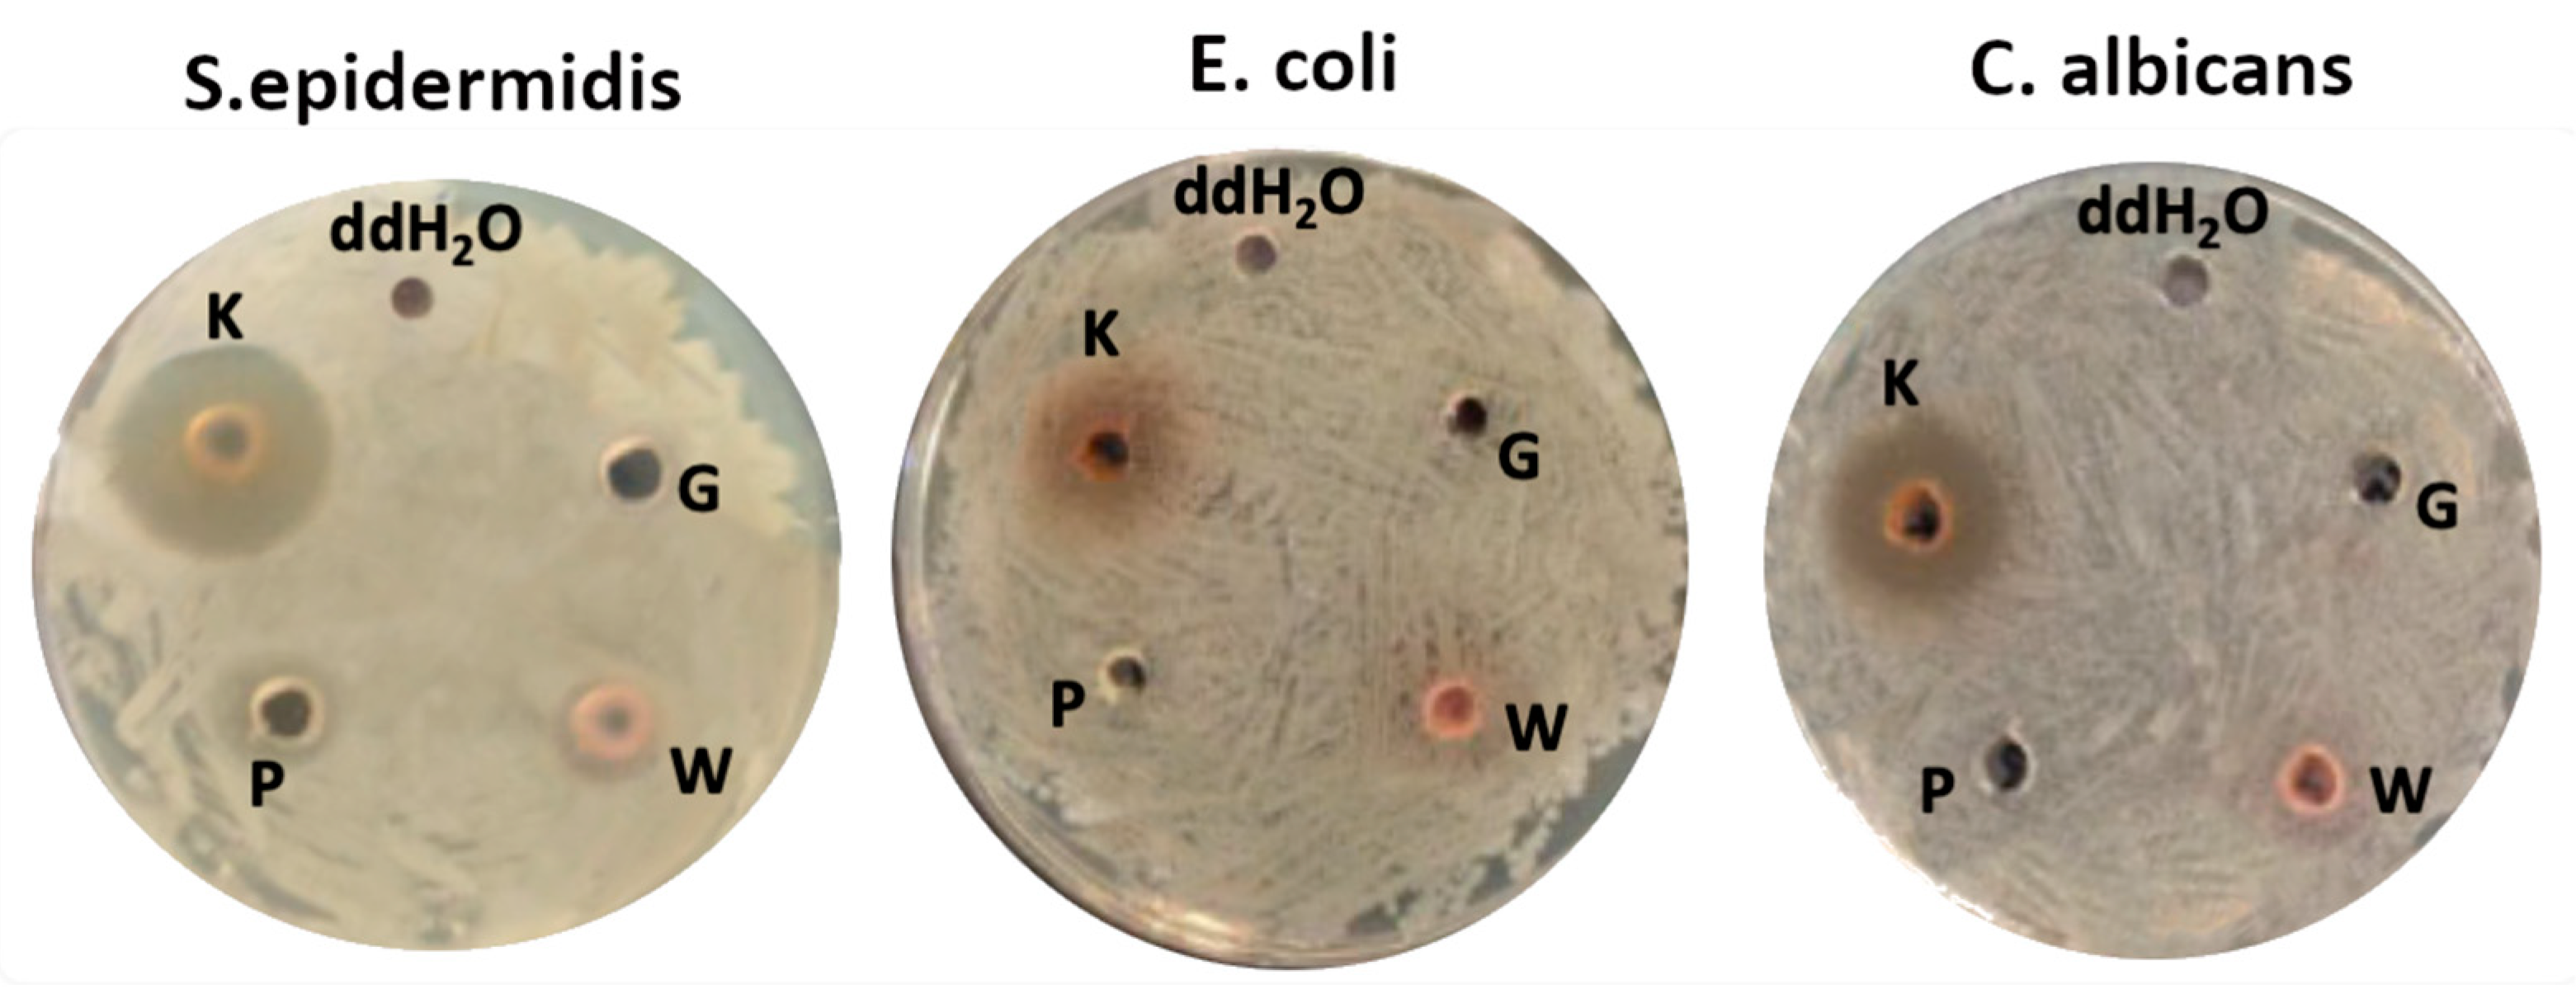
Ijms 25 12580 g001

Improving Antimicrobial Properties of Biopolymer-Based Films in Food Packaging: Key Factors and Their Impact
Abstract
1. Introduction
2. Results
2.1. Impact of Plant Extracts on Antimicrobial Properties
2.2. Impact of Other Modifiers on Antimicrobial Properties of Biopolymers Films
- (a)
- Nanofiber cellulose, and glycerol as a plasticizer for CH.
- (b)
- Oxidized sucrose as a cross-linking agent, and glycerol as a plasticizer for ST.
- (c)
- Calcium chloride as a cross-linking agent, and various plasticizers, i.e., glycerol; epoxidized soybean oil; epoxidized palm oil; mixed esters of propylene glycol and acetic acid; mixed esters of propylene glycol, oleic acid, and succinic acid; epoxidized mixed esters of propylene glycol; and oleic acid and succinic acid for ALG.
- (d)
- Oxidized sucrose as a cross-linking agent, and glycerol as a plasticizer for blends, i.e., STCH and STALG.
2.2.1. Impact of Polymer Matrix on Antimicrobial Activity
2.2.2. Impact of Plasticizers on Antimicrobial Activity
2.2.3. Impact of Cross-Linking Agents on Antimicrobial Activity
2.2.4. Impact of Nanofillers on Antimicrobial Properties
2.3. Impact of Mechanical Properties on Antimicrobial Properties
2.4. Impact of Hydrophilic Properties on Antimicrobial Properties
2.5. Biodegradation of Biopolymer-Based Films
3. Materials and Methods
3.1. Materials
3.2. Preparation of the Antimicrobial Films
3.2.1. Sodium Alginate Films
3.2.2. Plasticizer Mixtures
3.2.3. Starch Films
Oxidized Sucrose
3.2.4. Chitosan Films
3.2.5. Blend of Starch/Chitosan and Starch/Alginate Films
3.3. Measurement of Antimicrobial Properties
3.3.1. Plant Extracts Antimicrobial Activity
3.3.2. Polysaccharide Films’ Antimicrobial Activity
3.4. Measurement of Mechanical Properties
3.5. Measurement of Swelling Degree
3.6. Measurement of Contact Angle
3.7. Measurement of Biodegradation
4. Conclusions
Author Contributions
Funding
Institutional Review Board Statement
Informed Consent Statement
Data Availability Statement
Conflicts of Interest
References
- Ngo, T.M.P.; Nguyen, T.H.; Dang, T.M.Q.; Tran, T.X.; Rachtanapun, P. Characteristics and Antimicrobial Properties of Active Edible Films Based on Pectin and Nanochitosan. Int. J. Mol. Sci. 2020, 21, 2224. [Google Scholar] [CrossRef] [PubMed]
- Akinsemolu, A.A.; Onyeaka, H.N. Microorganisms Associated with Food Spoilage and Foodborne Diseases. In Food Safety and Quality in the Global South; Springer Nature: Singapore, 2024; pp. 489–531. [Google Scholar]
- Dilmaçünal, T.; Kuleaşan, H. Novel Strategies for the Reduction of Microbial Degradation of Foods. In Food Safety and Preservation; Elsevier: Amsterdam, The Netherlands, 2018; pp. 481–520. [Google Scholar]
- Omerović, N.; Djisalov, M.; Živojević, K.; Mladenović, M.; Vunduk, J.; Milenković, I.; Knežević, N.Ž.; Gadjanski, I.; Vidić, J. Antimicrobial Nanoparticles and Biodegradable Polymer Composites for Active Food Packaging Applications. Compr. Rev. Food Sci. Food Saf. 2021, 20, 2428–2454. [Google Scholar] [CrossRef] [PubMed]
- Deng, J.; Zhu, E.-Q.; Xu, G.-F.; Naik, N.; Murugadoss, V.; Ma, M.-G.; Guo, Z.; Shi, Z.-J. Overview of Renewable Polysaccharide-Based Composites for Biodegradable Food Packaging Applications. Green Chem. 2022, 24, 480–492. [Google Scholar] [CrossRef]
- Zhu, F. Polysaccharide Based Films and Coatings for Food Packaging: Effect of Added Polyphenols. Food Chem. 2021, 359, 129871. [Google Scholar] [CrossRef] [PubMed]
- Dursun Capar, T. Characterization of Sodium Alginate-Based Biodegradable Edible Film Incorporated with Vitis Vinifera Leaf Extract: Nano-Scaled by Ultrasound-Assisted Technology. Food Packag. Shelf Life 2023, 37, 101068. [Google Scholar] [CrossRef]
- Hernández-Hernández, F.A.; Gómez-Aldapa, C.A.; Castro-Rosas, J.; Vargas-León, E.A.; Gutierrez, M.C.; Velazquez, G.; Jiménez-Regalado, E.J.; Aguirre-Loredo, R.Y. Hibiscus Sabdariffa L. Extract as a Natural Additive in Food Packaging Biodegradable Films to Improve Antioxidant, Antimicrobial, and Physicochemical Properties. Plant Foods Human. Nutr. 2024, 79, 285–291. [Google Scholar] [CrossRef]
- Ma, M.; Gu, M.; Zhang, S.; Yuan, Y. Effect of Tea Polyphenols on Chitosan Packaging for Food Preservation: Physicochemical Properties, Bioactivity, and Nutrition. Int. J. Biol. Macromol. 2024, 259, 129267. [Google Scholar] [CrossRef]
- Elmehbad, N.Y.; Mohamed, N.A.; Abd El-Ghany, N.A.; Abdel-Aziz, M.M. Reinforcement of the Antimicrobial Activity and Biofilm Inhibition of Novel Chitosan-Based Hydrogels Utilizing Zinc Oxide Nanoparticles. Int. J. Biol. Macromol. 2023, 246, 125582. [Google Scholar] [CrossRef] [PubMed]
- da Costa Brito, S.; Pereira, V.A.C.; Prado, A.C.F.; Tobias, T.J.; Paris, E.C.; Ferreira, M.D. Antimicrobial Potential of Linear Low-Density Polyethylene Food Packaging with Ag Nanoparticles in Different Carriers (Silica and Hydroxyapatite). J. Microbiol. Methods 2024, 217–218, 106873. [Google Scholar] [CrossRef]
- Ponnusamy, A.; Rajasree, S.R.R.; Rajan, R.; Ashraf, F. Chitosan Silver Nanoparticle Inspired Seaweed (Gracilaria Crassa) Biodegradable Films for Seafood Packaging. Algal Res. 2024, 78, 103429. [Google Scholar] [CrossRef]
- Alqarni, L.S.; Alghamdi, A.M.; Elamin, N.Y.; Rajeh, A. Enhancing the Optical, Electrical, Dielectric Properties and Antimicrobial Activity of Chitosan/Gelatin Incorporated with Co-Doped ZnO Nanoparticles: Nanocomposites for Use in Energy Storage and Food Packaging. J. Mol. Struct. 2024, 1297, 137011. [Google Scholar] [CrossRef]
- Mirres, A.C.d.M.; Vieira, I.R.S.; Tessaro, L.; da Silva, B.D.; de Andrade, J.C.; da Silva, A.A.; Carvalho, N.M.F.; de Sousa, A.M.F.; Conte-Junior, C.A. Nanocomposite Films of Babassu Coconut Mesocarp and Green ZnO Nanoparticles for Application in Antimicrobial Food Packaging. Foods 2024, 13, 1895. [Google Scholar] [CrossRef]
- Gao, Y.; Fan, M.; Cheng, X.; Liu, X.; Yang, H.; Ma, W.; Guo, M.; Li, L. Deep Eutectic Solvent: Synthesis, Classification, Properties and Application in Macromolecular Substances. Int. J. Biol. Macromol. 2024, 134593. [Google Scholar] [CrossRef] [PubMed]
- Yu, J.; Xu, S.; Chen, R.; Shao, P. A Promising Bioactive Chitosan Film in Strawberry Fresh-Keeping: Plasticized with Tomato Processing by-Product Extract of Deep Eutectic Solvent. Food Hydrocoll. 2024, 151, 109859. [Google Scholar] [CrossRef]
- Jiang, G.; He, K.; Chen, M.; Yang, L.; Yang, Y.; Tang, T.; Tian, Y. Improvement of Mechanical and Bioactive Properties of Chitosan Films Plasticized with Novel Thymol-Based Deep Eutectic Solvents. Food Hydrocoll. 2025, 158, 110480. [Google Scholar] [CrossRef]
- Revutskaya, N.; Polishchuk, E.; Kozyrev, I.; Fedulova, L.; Krylova, V.; Pchelkina, V.; Gustova, T.; Vasilevskaya, E.; Karabanov, S.; Kibitkina, A.; et al. Application of Natural Functional Additives for Improving Bioactivity and Structure of Biopolymer-Based Films for Food Packaging: A Review. Polymers 2024, 16, 1976. [Google Scholar] [CrossRef]
- Silva, V.; Falco, V.; Dias, M.I.; Barros, L.; Silva, A.; Capita, R.; Alonso-Calleja, C.; Amaral, J.S.; Igrejas, G.; Ferreira, I.C.F.R.; et al. Evaluation of the Phenolic Profile of Castanea Sativa Mill. By-Products and Their Antioxidant and Antimicrobial Activity against Multiresistant Bacteria. Antioxidants 2020, 9, 87. [Google Scholar] [CrossRef]
- Mohammadian, M.; Biregani, Z.M.; Hassanloofard, Z.; Salami, M. Nettle (Urtica Dioica L.) as a Functional Bioactive Food Ingredient: Applications in Food Products and Edible Films, Characterization, and Encapsulation Systems. Trends Food Sci. Technol. 2024, 147, 104421. [Google Scholar] [CrossRef]
- Ivanov, Y.; Godjevargova, T. Antimicrobial Polymer Films with Grape Seed and Skin Extracts for Food Packaging. Microorganisms 2024, 12, 1378. [Google Scholar] [CrossRef]
- Srikandace, Y. Indriyati Antioxidant Activity of Biocellulose-Based Films Incorporated with Powder of Soursop Leaves (Annona Muricata L). IOP Conf. Ser. Earth Environ. Sci. 2019, 277, 012005. [Google Scholar] [CrossRef]
- Janik, W.; Nowotarski, M.; Ledniowska, K.; Shyntum, D.Y.; Krukiewicz, K.; Turczyn, R.; Sabura, E.; Furgoł, S.; Kudła, S.; Dudek, G. Modulation of Physicochemical Properties and Antimicrobial Activity of Sodium Alginate Films through the Use of Chestnut Extract and Plasticizers. Sci. Rep. 2023, 13, 11530. [Google Scholar] [CrossRef] [PubMed]
- Wang, X.; Li, Y.; Liu, S.; Wang, H.; Chang, X.; Zhang, J. Chestnut Shell Polyphenols Inhibit the Growth of Three Food-Spoilage Bacteria by Regulating Key Enzymes of Metabolism. Foods 2023, 12, 3312. [Google Scholar] [CrossRef] [PubMed]
- Štumpf, S.; Hostnik, G.; Primožič, M.; Leitgeb, M.; Salminen, J.-P.; Bren, U. The Effect of Growth Medium Strength on Minimum Inhibitory Concentrations of Tannins and Tannin Extracts against E. coli. Molecules 2020, 25, 2947. [Google Scholar] [CrossRef]
- Đurović, S.; Kojić, I.; Radić, D.; Smyatskaya, Y.A.; Bazarnova, J.G.; Filip, S.; Tosti, T. Chemical Constituents of Stinging Nettle (Urtica Dioica L.): A Comprehensive Review on Phenolic and Polyphenolic Compounds and Their Bioactivity. Int. J. Mol. Sci. 2024, 25, 3430. [Google Scholar] [CrossRef]
- Delgado, Y.; Cassé, C.; Ferrer-Acosta, Y.; Suárez-Arroyo, I.J.; Rodríguez-Zayas, J.; Torres, A.; Torres-Martínez, Z.; Pérez, D.; González, M.J.; Velázquez-Aponte, R.A.; et al. Biomedical Effects of the Phytonutrients Turmeric, Garlic, Cinnamon, Graviola, and Oregano: A Comprehensive Review. Appl. Sci. 2021, 11, 8477. [Google Scholar] [CrossRef]
- Aires, A.; Carvalho, R.; Saavedra, M.J. Valorization of Solid Wastes from Chestnut Industry Processing: Extraction and Optimization of Polyphenols, Tannins and Ellagitannins and Its Potential for Adhesives, Cosmetic and Pharmaceutical Industry. Waste Manag. 2016, 48, 457–464. [Google Scholar] [CrossRef] [PubMed]
- Vekiari, S.A.; Gordon, M.H.; García-Macías, P.; Labrinea, H. Extraction and Determination of Ellagic Acid Contentin Chestnut Bark and Fruit. Food Chem. 2008, 110, 1007–1011. [Google Scholar] [CrossRef]
- Pinto, N.; de, C.C.; Campos, L.M.; Evangelista, A.C.S.; Lemos, A.S.O.; Silva, T.P.; Melo, R.C.N.; de Lourenço, C.C.; Salvador, M.J.; Apolônio, A.C.M.; et al. Antimicrobial Annona Muricata L. (Soursop) Extract Targets the Cell Membranes of Gram-Positive and Gram-Negative Bacteria. Ind. Crops Prod. 2017, 107, 332–340. [Google Scholar] [CrossRef]
- Flórez, M.; Cazón, P.; Vázquez, M. Characterization of Active Films of Chitosan Containing Nettle Urtica Dioica L. Extract: Spectral and Water Properties, Microstructure, and Antioxidant Activity. Int. J. Biol. Macromol. 2023, 253, 127318. [Google Scholar] [CrossRef]
- Oliveira, D.A.; Salvador, A.A.; Smânia, A.; Smânia, E.F.A.; Maraschin, M.; Ferreira, S.R.S. Antimicrobial Activity and Composition Profile of Grape (Vitis Vinifera) Pomace Extracts Obtained by Supercritical Fluids. J. Biotechnol. 2013, 164, 423–432. [Google Scholar] [CrossRef]
- Elez Garofulić, I.; Malin, V.; Repajić, M.; Zorić, Z.; Pedisić, S.; Sterniša, M.; Smole Možina, S.; Dragović-Uzelac, V. Phenolic Profile, Antioxidant Capacity and Antimicrobial Activity of Nettle Leaves Extracts Obtained by Advanced Extraction Techniques. Molecules 2021, 26, 6153. [Google Scholar] [CrossRef] [PubMed]
- Sterniša, M.; Bucar, F.; Kunert, O.; Smole Možina, S. Targeting Fish Spoilers Pseudomonas and Shewanella with Oregano and Nettle Extracts. Int. J. Food Microbiol. 2020, 328, 108664. [Google Scholar] [CrossRef] [PubMed]
- Qin, C.; Li, H.; Xiao, Q.; Liu, Y.; Zhu, J.; Du, Y. Water-Solubility of Chitosan and Its Antimicrobial Activity. Carbohydr. Polym. 2006, 63, 367–374. [Google Scholar] [CrossRef]
- Hosseinnejad, M.; Jafari, S.M. Evaluation of Different Factors Affecting Antimicrobial Properties of Chitosan. Int. J. Biol. Macromol. 2016, 85, 467–475. [Google Scholar] [CrossRef] [PubMed]
- Wang, H.; Qian, J.; Ding, F. Emerging Chitosan-Based Films for Food Packaging Applications. J. Agric. Food Chem. 2018, 66, 395–413. [Google Scholar] [CrossRef]
- Jiang, A.; Patel, R.; Padhan, B.; Palimkar, S.; Galgali, P.; Adhikari, A.; Varga, I.; Patel, M. Chitosan Based Biodegradable Composite for Antibacterial Food Packaging Application. Polymers 2023, 15, 2235. [Google Scholar] [CrossRef]
- Chandrasekaran, M.; Kim, K.; Chun, S. Antibacterial Activity of Chitosan Nanoparticles: A Review. Processes 2020, 8, 1173. [Google Scholar] [CrossRef]
- Duan, C.; Meng, X.; Meng, J.; Khan, I.H.; Dai, L.; Khan, A.; An, X.; Zhang, J.; Huq, T.; Ni, Y. Chitosan as A Preservative for Fruits and Vegetables: A Review on Chemistry and Antimicrobial Properties. J. Bioresour. Bioprod. 2019, 4, 11–21. [Google Scholar] [CrossRef]
- Kumar, S.; Mukherjee, A.; Dutta, J. Chitosan Based Nanocomposite Films and Coatings: Emerging Antimicrobial Food Packaging Alternatives. Trends Food Sci. Technol. 2020, 97, 196–209. [Google Scholar] [CrossRef]
- Wang, M.; Wei, Z.; Zhang, Z. Antimicrobial Edible Films for Food Preservation: Recent Advances and Future Trends. Food Bioproc Tech. 2024, 17, 1391–1411. [Google Scholar] [CrossRef]
- Wang, X.; Zhang, H.; Zhang, X.; Shen, C.; Liu, M.; Liu, S.; Han, Y.; He, T. A Comparison Study on Effects of Polyglycerols on Physical Properties of Alginate Films. Int. J. Biol. Macromol. 2024, 254, 127879. [Google Scholar] [CrossRef] [PubMed]
- Motelica, L.; Ficai, D.; Oprea, O.; Ficai, A.; Trusca, R.-D.; Andronescu, E.; Holban, A.M. Biodegradable Alginate Films with ZnO Nanoparticles and Citronella Essential Oil—A Novel Antimicrobial Structure. Pharmaceutics 2021, 13, 1020. [Google Scholar] [CrossRef] [PubMed]
- Singh, P.; Kaur, G.; Singh, A.; Sharma, T.; Dar, B.N. Improved Mechanical, Functional and Antimicrobial Properties of Corn Starch-Based Biodegradable Nanocomposites Films Reinforced with Lemongrass Oil Nanoemulsion and Starch Nano-Crystal. Mater. Chem. Phys. 2023, 308, 128267. [Google Scholar] [CrossRef]
- Kalateh-Seifari, F.; Yousefi, S.; Ahari, H.; Hosseini, S.H. Corn Starch-Chitosan Nanocomposite Film Containing Nettle Essential Oil Nanoemulsions and Starch Nanocrystals: Optimization and Characterization. Polymers 2021, 13, 2113. [Google Scholar] [CrossRef] [PubMed]
- Alves, Z.; Ferreira, N.M.; Ferreira, P.; Nunes, C. Design of Heat Sealable Starch-Chitosan Bioplastics Reinforced with Reduced Graphene Oxide for Active Food Packaging. Carbohydr. Polym. 2022, 291, 119517. [Google Scholar] [CrossRef]
- Rahman, M.; Shahid, A.; Hossain, T.; Sheikh, S.; Rahman, S.; Uddin, N.; Rahim, A.; Khan, R.A.; Hossain, I. Sources, Extractions, and Applications of Alginate: A Review. Discov. Appl. Sci. 2024, 6, 443. [Google Scholar] [CrossRef]
- Zhang, M.; Chen, H. Development and Characterization of Starch-sodium Alginate-Montmorillonite Biodegradable Antibacterial Films. Int. J. Biol. Macromol. 2023, 233, 123462. [Google Scholar] [CrossRef]
- Yoon, B.; Jackman, J.; Valle-González, E.; Cho, N.-J. Antibacterial Free Fatty Acids and Monoglycerides: Biological Activities, Experimental Testing, and Therapeutic Applications. Int. J. Mol. Sci. 2018, 19, 1114. [Google Scholar] [CrossRef]
- Kester, J.F.O. Edible Films and Coatings: A Review. Food Technol. 1986, 40, 47–59. [Google Scholar]
- Hong, S.; Han, J.H.; Krochta, J.M. Optical and Surface Properties of Whey Protein Isolate Coatings on Plastic Films as Influenced by Substrate, Protein Concentration, and Plasticizer Type. J. Appl. Polym. Sci. 2004, 92, 335–343. [Google Scholar] [CrossRef]
- Muscat, D.; Adhikari, B.; Adhikari, R.; Chaudhary, D.S. Comparative Study of Film Forming Behaviour of Low and High Amylose Starches Using Glycerol and Xylitol as Plasticizers. J. Food Eng. 2012, 109, 189–201. [Google Scholar] [CrossRef]
- Bouftou, A.; Aghmih, K.; Lakhdar, F.; Abidi, N.; Gmouh, S.; Majid, S. Enhancing Cellulose Acetate Film with Green Plasticizers for Improved Performance, Biodegradability, and Migration Study into a Food Simulant. Meas. Food 2024, 15, 100180. [Google Scholar] [CrossRef]
- Yaman, M.; Yildiz, S.; Özdemir, A.; Yemiş, G.P. Multicomponent System for Development of Antimicrobial PLA-Based Films with Enhanced Physical Characteristics. Int. J. Biol. Macromol. 2024, 262, 129832. [Google Scholar] [CrossRef]
- Rajamma, S.B.; Raj, A.; Kalampalath, V.; Eapen, S.J. Elucidation of Antibacterial Effect of Calcium Chloride against Ralstonia Pseudosolanacearum Race 4 Biovar 3 Infecting Ginger (Zingiber Officinale Rosc.). Arch. Microbiol. 2021, 203, 663–671. [Google Scholar] [CrossRef]
- Janik, W.; Nowotarski, M.; Shyntum, D.Y.; Banaś, A.; Krukiewicz, K.; Kudła, S.; Dudek, G. Antibacterial and Biodegradable Polysaccharide-Based Films for Food Packaging Applications: Comparative Study. Materials 2022, 15, 3236. [Google Scholar] [CrossRef] [PubMed]
- Zhang, W.; Roy, S.; Ezati, P.; Yang, D.-P.; Rhim, J.-W. Tannic Acid: A Green Crosslinker for Biopolymer-Based Food Packaging Films. Trends Food Sci. Technol. 2023, 136, 11–23. [Google Scholar] [CrossRef]
- Yan, W.; Shi, M.; Dong, C.; Liu, L.; Gao, C. Applications of Tannic Acid in Membrane Technologies: A Review. Adv. Colloid. Interface Sci. 2020, 284, 102267. [Google Scholar] [CrossRef] [PubMed]
- Khan, A.; Gallah, H.; Riedl, B.; Bouchard, J.; Safrany, A.; Lacroix, M. Genipin Cross-Linked Antimicrobial Nanocomposite Films and Gamma Irradiation to Prevent the Surface Growth of Bacteria in Fresh Meats. Innov. Food Sci. Emerg. Technol. 2016, 35, 96–102. [Google Scholar] [CrossRef]
- Yadav, M.; Maurya, A.K.; Behera, K.; Chiu, F.-C.; Rhee, K.Y. Physical Properties of Cellulose Nanocrystal/Magnesium Oxide/Chitosan Transparent Composite Films for Packaging Applications. Int. J. Biol. Macromol. 2024, 264, 130560. [Google Scholar] [CrossRef]
- Zou, Z.; Ismail, B.B.; Zhang, X.; Yang, Z.; Liu, D.; Guo, M. Improving Barrier and Antibacterial Properties of Chitosan Composite Films by Incorporating Lignin Nanoparticles and Acylated Soy Protein Isolate Nanogel. Food Hydrocoll. 2023, 134, 108091. [Google Scholar] [CrossRef]
- Biratu, G.; Woldemariam, H.W.; Gonfa, G. Development of Active Edible Films from Coffee Pulp Pectin, Propolis, and Honey with Improved Mechanical, Functional, Antioxidant, and Antimicrobial Properties. Carbohydr. Polym. Technol. Appl. 2024, 8, 100557. [Google Scholar] [CrossRef]
- Sun, J.; Rutherford, S.T.; Silhavy, T.J.; Huang, K.C. Physical Properties of the Bacterial Outer Membrane. Nat. Rev. Microbiol. 2022, 20, 236–248. [Google Scholar] [CrossRef] [PubMed]
- Ali, A.; Chen, Y.; Liu, H.; Yu, L.; Baloch, Z.; Khalid, S.; Zhu, J.; Chen, L. Starch-Based Antimicrobial Films Functionalized by Pomegranate Peel. Int. J. Biol. Macromol. 2019, 129, 1120–1126. [Google Scholar] [CrossRef] [PubMed]
- Aloui, H.; Deshmukh, A.R.; Khomlaem, C.; Kim, B.S. Novel Composite Films Based on Sodium Alginate and Gallnut Extract with Enhanced Antioxidant, Antimicrobial, Barrier and Mechanical Properties. Food Hydrocoll. 2021, 113, 106508. [Google Scholar] [CrossRef]
- Abutalib, M.M.; Rajeh, A. Enhanced Structural, Electrical, Mechanical Properties and Antibacterial Activity of Cs/PEO Doped Mixed Nanoparticles (Ag/TiO2) for Food Packaging Applications. Polym. Test. 2021, 93, 107013. [Google Scholar] [CrossRef]
- Mathew, S.; Brahmakumar, M.; Abraham, T.E. Microstructural Imaging and Characterization of the Mechanical, Chemical, Thermal, and Swelling Properties of Starch–Chitosan Blend Films. Biopolymers 2006, 82, 176–187. [Google Scholar] [CrossRef]
- Giz, A.S.; Berberoglu, M.; Bener, S.; Aydelik-Ayazoglu, S.; Bayraktar, H.; Alaca, B.E.; Catalgil-Giz, H. A Detailed Investigation of the Effect of Calcium Crosslinking and Glycerol Plasticizing on the Physical Properties of Alginate Films. Int. J. Biol. Macromol. 2020, 148, 49–55. [Google Scholar] [CrossRef]
- Ma, Y.; Cao, X.; Feng, X.; Ma, Y.; Zou, H. Fabrication of Super-Hydrophobic Film from PMMA with Intrinsic Water Contact Angle below 90°. Polym. Guildf 2007, 48, 7455–7460. [Google Scholar] [CrossRef]
- Lakovaara, M.; Sirviö, J.A.; Ismail, M.Y.; Liimatainen, H.; Sliz, R. Hydrophobic Modification of Nanocellulose and All-Cellulose Composite Films Using Deep Eutectic Solvent as a Reaction Medium. Cellulose 2021, 28, 5433–5447. [Google Scholar] [CrossRef]
- Correlo, V.M.; Pinho, E.D.; Pashkuleva, I.; Bhattacharya, M.; Neves, N.M.; Reis, R.L. Water Absorption and Degradation Characteristics of Chitosan-Based Polyesters and Hydroxyapatite Composites. Macromol. Biosci. 2007, 7, 354–363. [Google Scholar] [CrossRef]
- Freier, T.; Koh, H.S.; Kazazian, K.; Shoichet, M.S. Controlling Cell Adhesion and Degradation of Chitosan Films by N-Acetylation. Biomaterials 2005, 26, 5872–5878. [Google Scholar] [CrossRef] [PubMed]
- Arica, B.; Çaliş, S.; Atİlla, P.; Durlu, N.T.; Çakar, N.; Kaş, H.S.; Hincal, A.A. In Vitro and in Vivo Studies of Ibuprofen-Loaded Biodegradable Alginate Beads. J. Microencapsul. 2005, 22, 153–165. [Google Scholar] [CrossRef]
- Azevedo, H.S.; Reis, R.L. Encapsulation of α-Amylase into Starch-Based Biomaterials: An Enzymatic Approach to Tailor Their Degradation Rate. Acta Biomater. 2009, 5, 3021–3030. [Google Scholar] [CrossRef] [PubMed]
- Wang, P.; Sheng, F.; Tang, S.W.; ud-Din, Z.; Chen, L.; Nawaz, A.; Hu, C.; Xiong, H. Synthesis and Characterization of Corn Starch Crosslinked with Oxidized Sucrose. Starch-Stärke 2018, 1800152. [Google Scholar] [CrossRef]
- Margesin, R.; Feller, G. Biotechnological Applications of Psychrophiles. Environ. Technol. 2010, 31, 835–844. [Google Scholar] [CrossRef] [PubMed]

| Chitosan films | |||||||||
|---|---|---|---|---|---|---|---|---|---|
| CH Chitosan with glycerol | CHNC Chitosan reinforced with nanofiber cellulose | CTRL CH Chitosan control without chestnut extract | |||||||
| Starch films | |||||||||
| ST Starch with glycerol | CTRL ST Starch control without chestnut extract | ||||||||
| Alginate films | |||||||||
| ALG Alginate with glycerol | ALG2 Alginate with epoxidized soybean oil | ALG3 Alginate with epoxidized palm oil | ALG4 Alginate with mixed esters of propylene glycol and acetic acid | ALG5 Alginate with mixed esters of propylene glycol, oleic acid, and succinic acid | ALG6 Alginate with epoxidized mixed esters of propylene glycol, oleic acid, and succinic acid | CTRL ALG Alginate control without chestnut extract | |||
| Blends | |||||||||
| STCH Starch and chitosan with glycerol | STALG Starch and alginate with glycerol | ||||||||
| Abbreviation | ALG | ALG2 | ALG3 | ALG4 | ALG5 | ALG6 |
|---|---|---|---|---|---|---|
| Plasticizer | Commercial | Commercial | Commercial | Synthesized | Synthesized | Synthesized |
| Description | Glycerol | Epoxidized soybean oil | Epoxidized palm oil | Mixed esters of propylene glycol and acetic acid | Mixed esters of propylene glycol, oleic acid, and succinic acid | Epoxidized mixed esters of propylene glycol, oleic acid, and succinic acid |
| Abbreviations | ALG | ST | CH | CHNC | STCH | STALG |
|---|---|---|---|---|---|---|
| Sample | Sodium alginate films | Starch films | Chitosan films | Chitosan films reinforced with nanofiber cellulose | Starch and chitosan films | Starch and alginate films |
Disclaimer/Publisher’s Note: The statements, opinions and data contained in all publications are solely those of the individual author(s) and contributor(s) and not of MDPI and/or the editor(s). MDPI and/or the editor(s) disclaim responsibility for any injury to people or property resulting from any ideas, methods, instructions or products referred to in the content. |
© 2024 by the authors. Licensee MDPI, Basel, Switzerland. This article is an open access article distributed under the terms and conditions of the Creative Commons Attribution (CC BY) license (https://creativecommons.org/licenses/by/4.0/).
Share and Cite
Wardejn, S.; Wacławek, S.; Dudek, G. Improving Antimicrobial Properties of Biopolymer-Based Films in Food Packaging: Key Factors and Their Impact. Int. J. Mol. Sci. 2024, 25, 12580. https://doi.org/10.3390/ijms252312580
Wardejn S, Wacławek S, Dudek G. Improving Antimicrobial Properties of Biopolymer-Based Films in Food Packaging: Key Factors and Their Impact. International Journal of Molecular Sciences. 2024; 25(23):12580. https://doi.org/10.3390/ijms252312580
Chicago/Turabian StyleWardejn, Sonia, Stanisław Wacławek, and Gabriela Dudek. 2024. "Improving Antimicrobial Properties of Biopolymer-Based Films in Food Packaging: Key Factors and Their Impact" International Journal of Molecular Sciences 25, no. 23: 12580. https://doi.org/10.3390/ijms252312580
APA StyleWardejn, S., Wacławek, S., & Dudek, G. (2024). Improving Antimicrobial Properties of Biopolymer-Based Films in Food Packaging: Key Factors and Their Impact. International Journal of Molecular Sciences, 25(23), 12580. https://doi.org/10.3390/ijms252312580

